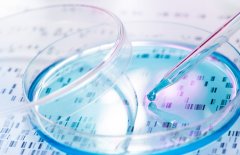
第三代试管可以排除哪些遗传病

试管科普

-
 福建借卵试管好吗?福建借卵试管口碑不错的医院有哪些?
福建借卵试管好吗?福建借卵试管口碑不错的医院有哪些?福建借卵试管是指,女性把卵子卖给另一个人。这种方式能够帮助那些有生育梦想的人有机会实现自己的梦想。然而,它也存在着一些弊端。 福建借卵试管的危害 借卵有可能会威胁女性的健康
作者:兰兰 65 发布时间:2026-05-11 -
 有白化病可以试管吗?有白化病能不能选男女?
有白化病可以试管吗?有白化病能不能选男女?白化病(cysticfibrosis)是一种常染色体隐性遗传疾病,它是一种慢性病,主要影响肺部和消化道,其病人一般会患有肺部疾病、慢性肺炎或肺部感染等疾病,而且会影响其正常的生活质量。白化病
作者:兰兰 115 发布时间:2026-05-11 -
 福建借卵试管合法吗?福建借卵试管需要花费多少钱?
福建借卵试管合法吗?福建借卵试管需要花费多少钱?每个夫妇都期望能拥有一个自己的宝宝,但是随着社会发展,女性生育年龄越来越大,有很多夫妻无法通过自身生育。在这种情况下,借卵试管可以让期望父母得到一个宝贵的希望。 福建借卵
作者:兰兰 186 发布时间:2026-05-11 -
 做试管之前必须了解的前期检查项目和时间
做试管之前必须了解的前期检查项目和时间试管技术是一种辅助生殖方法,该技术需要对男女双方进行一系列的身体检查,以确定是否适合进行试管治疗。那么在进行试管治疗前,男女方体检需要提前多久呢? 试管前男女方
作者:木易 197 发布时间:2026-05-11 -
 试管积水结扎详细步骤,附试管结扎风险
试管积水结扎详细步骤,附试管结扎风险试管积水结扎是一种辅助生殖技术,常用于治疗输卵管不通或损伤等导致不孕不育的情况。该技术旨在帮助患者成功怀孕并生育健康宝宝。下面我们来了解一下试管积水结扎的详细过
作者:木易 154 发布时间:2026-05-11 -
 福建做试管有不错的吗?福建做试管能选男女吗?
福建做试管有不错的吗?福建做试管能选男女吗?随着科学技术的发展,有越来越多的人希望能够通过试管预先确定胎儿的性别。那么在福建,哪家医院可以做试管可以选择性别呢? 福建哪有做试管 福建省尤溪县东山镇梅湖社区医院是一
作者:兰兰 138 发布时间:2026-05-11 -
 私人医院试管靠谱吗?私人医院做试管需要准备什么?
私人医院试管靠谱吗?私人医院做试管需要准备什么?随着科学技术的发展,试管已经成为一种解决不能怀孕的可行方案。然而,有许多不同的治疗方法,它们在不同的私人医院中应用有所不同。那么私人医院试管需要三证吗? 要了解的是
作者:兰兰 126 发布时间:2026-05-11 -
 试管后需要注意什么?试管后哪些行为不能有?
试管后需要注意什么?试管后哪些行为不能有?试管已成为几十年来治疗不孕不育的最有效方法,它的出现帮助无数不孕不育的夫妻实现了梦想。但是试管后,妈妈们应该遵循哪些护理措施,以保障孩子的健康?试管后不能长期坐着
作者:兰兰 199 发布时间:2026-05-11 -
 出血了!移植的胚胎还能保住吗?
出血了!移植的胚胎还能保住吗?试管技术已经成为许多不孕不育家庭的福音,但是在整个过程中也存在一些风险,例如试管出血。那么试管出血了还能保住吗? 试管出血原因 可能的原因 试管出血的原因
作者:木易 172 发布时间:2026-05-11 -
 试管需要吃些什么?需要摄入蛋白粉吗?
试管需要吃些什么?需要摄入蛋白粉吗?近年来,不少家庭选择用试管的方式来实现孩子的梦想。而在抚养这些孩子的过程中,家长也会面临很多问题,其中一个就是,试管要喝蛋白粉吗? 首先要澄清的是,蛋白质是试管
作者:兰兰 96 发布时间:2026-05-11 -
第三代试管可以排除哪些遗传病
第三代试管可以排除哪些遗传病随着科技的不断发展,人类对于遗传病的治疗也越来越进步。三代试管技术就是一种新型的生殖医学技术,可以针对携带遗传病基因的夫妇,在人工受孕过程中排除这些遗传病。那么三代试管
作者:木易 81 发布时间:2026-05-11 -
 试管双胞胎安全吗?试管双胞胎会不会影响胎儿发育?
试管双胞胎安全吗?试管双胞胎会不会影响胎儿发育?随着科学技术的发展,试管技术已经成为人们非常普遍的生育方式之一。那么试管可以双胞胎吗? 答案是肯定的。试管可以双胞胎,这是通过多囊卵子技术实现的。在这一技术中,
作者:兰兰 189 发布时间:2026-05-11
